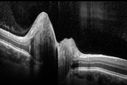
ODD_mafr_05161310.jpg

|
|

Choroidal Melanoma - Exudative Retinal Detachment 82 Year Old Man B Scan Ultrasound Longitudinal824 views82-year-old man who had 3 falls 2 weeks ago. After the falls he started checking his vision and noticed there was a veil over the left eye, which he had seen for about two weeks in the superior visual field. OD 20/25, OS 20/40
(patient was medically never well enough for brachytherapy and died 6 months later from heart disease)
|
|

Optic Nerve Pit Retinal Detachment - Macular Detachment - 8 Year Old - Fresh Laser824 views8-year-old child on two school exams that his vision was poor in the left eye and his last normal exam was in preschool.
VISUAL ACUITY: OD 20/30, OS 5/200. OS: Vertical C/D ratio is 0.2. There is a whitening on the temporal edge of the optic nerve consistent with an optic disc pit and there is a serous macular detachment.
No better after 3 months observation.
|
|
Optic Nerve (Disc) Drusen - Spectral Domain Optical Coherence Tomography Line Scan824 views34 Year Old woman no headaches normal vision
|
|

Central Retinal Venous Occlusion with Papilledema, Intraretinal Hemorrhage and Macular Edema824 views
|
|

Ghost Cell Glaucoma824 viewsPost cataract surgery, patient presents with ghost cell in the anterior chamber after hemorrhage cleared. A small hyphema still is visible in the anterior chamber with a whitish ball appearance.
|
|

PDR - Preretinal Fibrosis823 views58-year-old woman has diabetic retinopathy in both eyes with neovascularization of the optic nerve, worse in the right eye than the left eye. She has had panretinal laser in both eyes and vitreous hemorrhage in the left eye. Her vision, since I saw her last in June, is about the same.
VISUAL ACUITY: Vision OD is 20/25, OS is 20/20.
|
|

Plaquenil Toxicity - Bull's Eye Maculopathy - 25 Years Therapy - OCT Video - TAKES TIME TO LOAD823 views73-year-old woman has been on Plaquenil for twenty five years. Plaquenil has now been stopped for 6 months. VA continues to decline as does visual function - 20/80 OD , 20/40 OS
|
|

Bilateral Diffuse Uveal Melanocytic Proliferation - BDUMP - Paraneoplastic Syndrome822 views80-year-old man vision loss for one year. He died about one year after these photos from Metastatic Poorly Differentiated Large Cell Carcinoma of unknown primary. He was a smoker.
|
|

Choroidal Nevus in Macula 822 views
|
|

Clinically Significant Diabetic Macular Edema both Eyes with Exudates822 views56-year-old woman with diabetes for twelve years. She has noticed blurring of the vision in the right eye for about six months. OD is 20/70, OS is 20/25.
|
|

Serpiginouse Choroiditis (Chorioretinitis) - Acute Right Eye - Old Left Eye VA 20/25 OD , 20/50 OS822 views63-year-old woman has serpiginous choroiditis (date - March 2011). The right eye has not been previously involved, and then she noticed new onset floaters in the right eye for the last two weeks. Her vision in the right eye is hazy because of that.
VISUAL ACUITY: Vision OD is 20/25, OS is 20/50
|
|

Giant Retinal Tear with Detachment822 views
|
|

Post-Op Vitrectomy with Membrane Stripping and Laser822 viewsPatient had surgery to help clear up some vision in the left eye. Pre-op VA was count fingers at 1-ft. Post op VA was 20/200 in the left eye. Patient will return in 3-months for follow-up.
|
|

Idiopathic Cystoid Macular Edema - Mid Phase Fluorescein Angiogram Showing Leakage of Dye into Center of Macula821 views49-year-old man had a flu two weeks ago the right eye has been throbbing and his vision in the right eye has been foggy. OD 20/80, OS 20/40. IOP: 14 OU.
|
|

Myopic Choroidal Neovascular Membrane 54 year old woman 20/20821 views54-year-old woman has had problems in her vision in the right eye for about the last three months. Inferotemporally she sees a gray area, which is distorted. OD is 20/20, OS is 20/20
|
|

Acute Zonal Occult Outer Retinopathy821 views45-year-old man noticed a few years ago peripheral vision blurriness in the left eye and also some central vision loss. Previous to that, as far as he knows, the two eyes were okay.
VISUAL ACUITY: OD: 20/20; OS: 20/40.
|
|

Choroidal Rupture - Hit with Branch - 11 Year Old Boy821 views 11-year-old had a choroidal rupture in the left eye with a macular hemorrhage 4 months ago. He had a rupture globe repair. Vision has improved some. VISUAL ACUITY: OS 20/200.
1 year later Vision was 20/30
|
|

Chorioretinal Scar with Radiating Chorioretinal Folds821 views79-year-old woman has wet age-related macular degeneration in both eyes. The left eye had intravitreal injections of Avastin starting in May of 2009. Her vision remains good in the left eye and poor in the right eye.
VISUAL ACUITY: OD 8/200, OS 20/60.
|
|

Acute Central Serous Retinopathy - CSR - Steroid Induced (probably) - Good Vision - Fundus HyperAutofluorescence Serous Retinal Detachment821 views42-year-old man was seen in the office on October 5, 2011. He had noticed starting in August after a course of antibiotic and steroids, that he developed new spots in his vision in the right eye. He may have had an episode like this sometime in the past. He did take steroids a few years ago and his vision did change at that time, but then returned.
VISUAL ACUITY: OD 20/32, OS 20/32. The OCT scan of the right eye confirms subretinal fluid.
|
|

Posterior Polar Annular Choroidal Dystrophy821 views68 year old woman with know macular irregularities for over 20 years. She has since been followed another 6 years and her vision remains 20/25.
|
|

Ciliary Body Melanoma821 views71-year old male who was recently diagnosed with a large ciliary body melanoma that is pushing into the anterior chamber of the left eye. Patient is going to proceed with proton therapy.
|
|

Outer Retinal Holes - Probably Solar Retinopathy (history is negative)821 views
|
|

Subfoveal CNVM wet AMD early fa (contrast enhanced with photoshop)820 viewsShe has noticed decreased vision in the left eye. It is hard to say for how long, maybe a few months. She had her last eye exam about a year ago. She thoughts perhaps it was cataracts, but you saw a problem with the macula and suggested she come here for evaluation.
VISUAL ACUITY: Vision OD is 20/25, OS is 2/200
|
|

Myopic Degeneration - Staphyloma - Atrophy820 views53-year-old man was a -15.00 myope. He is aphakic. His left eye also had a retinal detachment repair and unfortunately the left eye does not see well. He is on Timolol in both eyes for glaucoma. VISUAL ACUITY: OD 20/50, OS: Faint light perception.
|
|

Serpiginouse Choroiditis (Chorioretinitis) - Acute Right Eye - Old Left Eye VA 20/25 OD , 20/50 OS820 views63-year-old woman has serpiginous choroiditis (date - March 2011). The right eye has not been previously involved, and then she noticed new onset floaters in the right eye for the last two weeks. Her vision in the right eye is hazy because of that.
VISUAL ACUITY: Vision OD is 20/25, OS is 20/50
|
|

Cuticular Drusen (Basal Laminar Drusen) and Bilateral Chronic Subfoveal Fluid (Serous Retinal Detachment) unresponsive to monthly Avastin - Fundus Autofluorescence OD820 views66-year-old man with bilateral subfoveal fluid unresponsive to one year of monthly avastin therapy.
OD 20/160, Pinhole 20/80. OS 20/63, Pinhole 20/50. OCT scan shows subretinal fluid with normal choroidal thickness. Fluorescein angiogram shows cuticular/basal laminar drusen. ICG shows no foci of choriocapillaris leakage.
|
|

Angioid Streaks - Peau D'Orange - Pseudoxanthoma Elasticum - Asymptomatic Extrafoveal Choroidal Neovascular Membrane820 views60-year-old woman has pseudoxanthoma elasticum since 2008. Her sister has the same problem and lost vision in both eyes. She had a problem with blood vessel growth in the left eye for which she had injections of Avastin in August, September, and October of 2011 (5 months ago). Subsequent to that, the macula has been dry and you have just been watching her carefully. She is in Florida for a short time but will ultimately be spending nine months out of the year here. Both of her eyes have good vision at
|
|

Acute Posterior Multifocal Placoid Pigment Epitheliopathy - APMPPE - Indocyanine Green Angiogram820 views 25-year-old man with one and half weeks ago he woke up with night chills. Also around that time his joints started hurting him. He also has headaches, although the headache at this point is not severe. His vision has been changing for about the last week and a half. He sees some spots in his vision and they are blurred spots. They are not in the central vision.
VISUAL ACUITY: OD 20/32, OS 20/32
|
|

Ghost Cell Glaucoma820 viewsPost cataract surgery, patient presents with ghost cell in the anterior chamber after hemorrhage cleared. A small hyphema still is visible in the anterior chamber with a whitish ball appearance.
|
|

Unilateral Acute Idiopathic Maculopathy (UAIM)820 views1 week later eye looks better (after initial scan) 41 year old with serous retinal detachment OS and sudden vision loss. He had a viral prodrome. Coxscackie IgG was high but no acute infection was documented. Vision improved in about 2 months without therapy. - Right eye has spot nasal to the optic nerve
|
|

Classic Subfoveal Choroidal Neovascular Membrane - 20/400 Vision - 6 - 12 months old lesion819 views78-year-old woman six months or a year ago decreasing vision in the right eye. OD 20/400. Fluorescein angiography shows a classic subfoveal choroidal neovascular membrane in the right eye 3 disc-diameters across, which has brisk leakage. The left eye shows staining drusen.
|
|

Atypical Birdshot Chorioretinitis and Retinal Arterial Macroaneurysm Right Eye - HLA-B29 Positive819 views55-year-old woman has multifocal choroiditis in both eyes because she was HLA A-29 positive. She has presumptive birdshot chorioretinopathy. She has not noticed any vision changes. OD 20/40, OS 20/20.
|
|

69 Year Old Woman Normal OCT819 views69-year-old woman OD 20/50 - OS 20/30 ATYPICAL PHOTOPSIAS
|
|

Acute Annular Outer Retinopathy - VA loss 2 days Right Eye Only - 25 Year Old Woman- AZOOR - White Line Around Fresh Lesions819 viewsInitial visit (June 11, 2011): 2 days of vision loss right eye. Wedge suddenly of VA loss OD, too dardkto see through. No flashes or floaters. VA 20/20 OU.
|
|

Congenital Achromatopsia 819 views26-year-old man was diagnosed with congenital achromatopsia by ERG as a child. He has family members who also have this disorder. OD 20/200, OS 20/200.
|
|

CMV secondary to HIV819 views36 yr old Female Presents for reassessment of decreased vision after starting antiviral medication. OD Va @ onset was LP> OS Va stable 20/20.
|
|

Drusen Maculopathy - Confluent Subfoveal Soft Hydrophobic Drusen - OCT Line Scan Shows Thickening Under Retina with Retinal Thinning818 views73-year-old woman. She is diabetic for thirteen years. She is also on Coumadin for her heart disease.
VISUAL ACUITY: OD 20/25, OS 20/50.
|
|

Atypical Birdshot Chorioretinitis and Retinal Arterial Macroaneurysm Right Eye - HLA-B29 Positive818 views55-year-old woman has multifocal choroiditis in both eyes because she was HLA A-29 positive. She has presumptive birdshot chorioretinopathy. She has not noticed any vision changes. OD 20/40, OS 20/20.
|
|

Diabetic Retinopathy - Foveal Laser Scar Right Eye818 views74-year-old woman has diabetic retinopathy in both eyes. She has had focal laser in her right eye done elsewhere in the mid 90’s and unfortunately the laser was fairly close to the center and as time progressed she developed foveal atrophy around the scars. She has noticed her vision declining since she was here last a year ago. She does take Travatan in both eyes at night for glaucoma.
VISUAL ACUITY: OD 20/200, OS 20/40.
|
|

Choroidal Metastases - Both Eyes - Exudative Retinal Detachment818 views58-year-old man smoke a pack of cigarettes a day. He has had some ribcage pain for about the last two weeks. He also had a sinus infection for about two weeks, and he has also had hazy vision on the superior visual field in the left eye for about the last two weeks. vision is 20/25 in both eyes
|
|

Central Retinal Vein Occlusion818 views
|
|

Pre-retinal hemorrhage following Posterior Vitreous Detachment (separation - PVD)818 views68 year old woman with acute PVD OD and new preretinal hemorrhage - also there is a macular nevus
|
|

Bilateral Diffuse Uveal Melanocytic Proliferation - BDUMP - Paraneoplastic Syndrome817 views80-year-old man vision loss for one year. He died about one year after these photos from Metastatic Poorly Differentiated Large Cell Carcinoma of unknown primary. He was a smoker.
|
|

Retinal Arterial Macroaneurysm - Increased Swelling after Laser 817 viewsVisit 3 - 4 months post laser:
on May 23, 2011. This pleasant 66-year-old woman had a leaky arterial macroaneurysm I lasered in January. She developed more swelling subsequently, but an angiogram showed the lesion was closed. Since then she has noticed her vision poor in the eye.
VISUAL ACUITY: OD 20/200
|
|

Best Disease - Color Fundus Photo817 views
|
|

Central Areolar Choroidal Dystrophy817 viewsVision loss from early 60's. This 78 year old woman has choroidal atrophy centrally.
|
|

Retinoblastoma - Bilateral - Regressed - Chemotherapy, Thermal Therapy, Cryotherapy816 views10-year-old child was seen in the office on August 6, 2008. She was treated with a combination of chemotherapy at 10 months old as well as thermal therapy and cryotherapy for bilateral retinoblastoma tumors. She reportedly had nine tumors in the left eye and five tumors in the right eye
|
|

AMD - Wet - Fibrovascular Hemorrhagic PED - Occult CNVM816 views87-year-old woman for one month OS: 20/60 Fibrovascular PED and Hemorrhage
|
|

Atypical Birdshot Chorioretinitis and Retinal Arterial Macroaneurysm Right Eye - HLA-B29 Positive816 views55-year-old woman has multifocal choroiditis in both eyes because she was HLA A-29 positive. She has presumptive birdshot chorioretinopathy. She has not noticed any vision changes. OD 20/40, OS 20/20..
|
|

Pathology - Central Retinal Artery Occlusion - 6 weeks old - Inner Retinal Atrophy - Macular Pucker816 viewspatient died about 6 to 8 weeks after the artery occlusion, and he had no history of glaucoma. The inner retina atrophy, which looks very similar to that caused by COAG, is due to recent infarct.
|
|

Eccentric Disciform Scar - Breakthrough Vitreous Hemorrhage - InferoTemporal Subretinal Fibrosis - Ectopic Choroidal Neovascular Membranes816 views88-year-old man has noticed for the last few months the vision in the right eye is foggy, like there is a film in the eye or a haze, His vision is 20/16 in each eye.
Right eye - inferotemporal periphery there is a hemorrhage at the equator at about 7:00 o’clock, which is about 4-disc diameters across and adjacent to that there is scarring.
Left eye - large disciform scar inferotemporally
|
|

Macular Branch Retinal Vein Occlusions (2) Left Eye - No Macular Edema (yet) 816 views77-year-old woman with two macular branch retinal vein occlusions in the left eye OD 20/25
|
|

Acute Cytomegalovirus Retinitis816 views45 y/o male presents with newly diagnosed AIDS and retinal infiltrates.
|
|

Juxtafoveal Retinal Telangiectasia (Telangiectasis) - MacTel - Striking Gray Ring in Macula - Funuds Autofluorescence816 views59-year-old woman decreasing vision in the right eye for a few years. She has had diabetes for five years. OD 20/100, Pinhole 20/40. OS 20/20
|
|

Central Retinal Artery Occlusion with Cilioretinal Sparing - Acute816 views 77-year-old man was doing fine until midnight of last night when he noticed sudden severe vision loss in the left eye. VISUAL ACUITY: OD 20/20, OS 2/200.
|
|

Gonioscopy, Blood in the Anterior Chamber from Hyphema816 viewsPatient comes in with blunt trauma to the right eye due to a BB gun incident. Patient was present with a hyphema at 8-o'clock about 1mm thick. Gonioscopy photos were then taken to show blood from the hyphema entered into the anterior chamber. Patient had no angle recession in the right eye.
|
|

Cartwheel CNVM - Classic - wet AMD - evidence of possible old CSR - Autofluorescence shows brigh spot superior to subfoveal lesion816 views75 y.o Decreased Vision right eye for one year. VA OD: sc20/125+2 OS 20/25. Autofluorescence and SD OCT show evidence of old serous retinal detachment superior to the fovea suggesting a history of CSR. The macular lesion on FA shows a classic cartwheel appearance
|
|

telangiectasia816 views20/20 pt with blurry area in va
|
|

Acute Zonal Occult Outer Retinopathy815 views45-year-old man noticed a few years ago peripheral vision blurriness in the left eye and also some central vision loss. Previous to that, as far as he knows, the two eyes were okay.
VISUAL ACUITY: OD: 20/20; OS: 20/40.
|
|

Acute Annular Outer Retinopathy - VA loss 2 days Right Eye Only - 25 Year Old Woman- AZOOR - White Line Around Fresh Lesions815 viewsInitial visit (June 11, 2011): 2 days of vision loss right eye. Wedge suddenly of VA loss OD, too dardkto see through. No flashes or floaters. VA 20/20 OU.
|
|

Idiopathic CNVM in 6 year old girl815 viewsCNVM in OD of a 6 yr old girl
|
|

69 Year Old Woman Normal Fluorescein Angiogram814 views69-year-old woman OD 20/50 - OS 20/30 ATYPICAL PHOTOPSIAS
|
|

Diabetic Macular Edema and Hypertensive Retinopathy - Circinate Exudate (Ring Exudate) 814 views55-year-old woman diabetic for fifteen years and high blood pressure, especially over the last few months. She has had problems with nosebleeds, headaches, and there has been some difficulty bringing her blood pressure down. She said now the blood pressure is under control but it was running 220/120 mmHg for some time. Her vision in the right eye has been poor for four weeks with a spot in the central vision and both eyes have been blurred.
VISUAL ACUITY: Vision OD is 20/160, OS is 20/60
|
|

Retinal Arterial Macroaneurysm - Increased Swelling after Laser 814 views65-year-old woman was seen in the office on January 12, 2011. She has noticed decreased vision in the right eye for the last two or three weeks. She has had some discomfort in both eyes as well. She has a history of low blood pressure, but she does have high cholesterol.
VISUAL ACUITY: OD 20/60
|
|

Fundus Photograph - Enhanced S Cone Syndrome - Goldmann Favre - 814 views55-year-old woman while in college her vision was poor even with glasses and she sought evaluation for that. She was told after she had an electroretinogram at USF 15 years ago, that she had something with her blue cones. She does have poor night vision, but her reading vision is pretty good.
VISUAL ACUITY: OD 20/40, OS 20/40
|
|

Regressed Proliferative Diabetic Retinopathy with Recurrent Vitreous Hemorrhage from Vitreoretinal Traction over a Major Retinal Vessel (Vein)814 views56-year-old woman has had recurrent vitreous hemorrhage in the left eye from vitreoretinal traction. Diabetes Mellitus for 20 years and excellent response to vitrectomy in the right eye about 1 year ago for recurrent vitreous hemorrhage from traction over a major retinal vessel.
VISUAL ACUITY: Vision OS is 20/200
|
|

Cornea Ulcer scar814 views
|
|

Choroidal Osteoma814 viewsYoung girl with vision loss from osteoma.
|
|

Polychromatic "Christmas Tree" Cataract814 viewsPatient comes in for annual eye exam. Eval on cataracts. VA is 20/20, right eye, 20/40, left eye. Slit Lamp exam shows polychromatic christmas tree cataract in the left eye.
|
|

Outer Retinal Holes - Probably Solar Retinopathy (history is negative)814 views
|
|

Presumed Ocular Histoplasmosis with new CNVM in right and better eye - VA 20/80 OD; 20/800 OS814 viewsMacular scar 20 years old
|
|

BRVO with collaterals and cystoid macular edema813 views66 Year Old Man with has had a branch retinal vein occlusion in the right eye with vision loss for the last few months. OD is 20/40, OS is 20/20. IOP: OD 18, OS 19. There is a superotemporal macular branch retinal vein occlusion with edema, hemorrhage, and exudate.
OCT SCAN: The right eye shows edema with a central foveal thickness of 354 microns FA: shows remodeling of the superotemporal vasculature. There are already venous-venous collaterals, suggesting the vein occlusion may be a little more than a few months old. There are multiple microaneurysms superotemporal to the fovea, and there is leakage in the late frames involving the fovea.
|
|

Retinoblastoma - Bilateral - Regressed - Chemotherapy, Thermal Therapy, Cryotherapy813 views10-year-old child was seen in the office on August 6, 2008. She was treated with a combination of chemotherapy at 10 months old as well as thermal therapy and cryotherapy for bilateral retinoblastoma tumors. She reportedly had nine tumors in the left eye and five tumors in the right eye
|
|

Central Serous Retinopathy - Acute813 views49-year-old man sees a spot in the central vision with a red halo for 2 weeks OD is 20/50, OS is 20/20
|
|

Plaquenil Toxicity - Bulls Eye Maculopathy813 views70-year-old woman with systemic Lupus erythematosus and clotting problems. She was on the Plaquenil for about eight years and then off the Plaquenil for the last eight years because she developed macular toxicity. Although her vision was hazy, it was stable. Recent deceased vision left eye: OD 20/60, OS 20/100. IOP: OD 18, OS 19.
|
|

Vitreomacular Traction - Macular Pucker - 20/50 Vision813 views75-year-old woman decreasing vision in the right eye a few months ago. She had her cataract removed and unfortunately her vision is still hazy in the right eye. Her left eye seems a little hazy from the cataract.
VISUAL ACUITY: OD 20/50, OS 20/20. IOP: OD 17, OS 18.
SLIT-LAMP EXAMINATION
|
|

Idiopathic Central Serous Retinopathy - Bilateral - Acute 813 views49-year-old man decreasing vision in the left eye for one week. He is not taking any steroid or steroid-related products. His blood pressure as far as he knows is under control.
VISUAL ACUITY: OD 20/30, OS 20/400
|
|

Acute Annular Outer Retinopathy - VA loss 2 days Right Eye Only - 25 Year Old Woman- AZOOR - White Line Around Fresh Lesions813 viewsInitial visit (June 11, 2011): 2 days of vision loss right eye. Wedge suddenly of VA loss OD, too dardkto see through. No flashes or floaters. VA 20/20 OU.
|
|

Acute Posterior Multifocal Placoid Pigment Epitheliopathy - APMPPE - Fluorescein Angiogram813 views 25-year-old man with one and half weeks ago he woke up with night chills. Also around that time his joints started hurting him. He also has headaches, although the headache at this point is not severe. His vision has been changing for about the last week and a half. He sees some spots in his vision and they are blurred spots. They are not in the central vision.
VISUAL ACUITY: OD 20/32, OS 20/32
|
|

Progressive Outer Retinal Necrosis 77 Year Old Woman with CLL (Acute Retinal Necrosis) (PORN - ARN)812 views77-year-old woman with CLL who had shingles on the left side of her face about 6 weeks ago then she developed a dendrite in the cornea which was treating about four weeks ago. She noticed severe vision loss in the left eye just a few days ago and you saw retinitis and she comes in because of that. Vision OD is 20/25, OS is hand motion
|
|

Microaneurysms from Ocular Ischemic Syndrome (non-diabetic) Right Eye - Left eye CRAO 1 year ago812 views66-year-old woman lost vision in the left eye from a central retinal artery occlusion 1 year ago. Vision OD is fine. OD 20/25, OS 20/50
|
|

Angioid Streaks - Peau D'Orange - Pseudoxanthoma Elasticum - Asymptomatic Extrafoveal Choroidal Neovascular Membrane812 views60-year-old woman has pseudoxanthoma elasticum since 2008. Her sister has the same problem and lost vision in both eyes. She had a problem with blood vessel growth in the left eye for which she had injections of Avastin in August, September, and October of 2011 (5 months ago). Subsequent to that, the macula has been dry and you have just been watching her carefully. She is in Florida for a short time but will ultimately be spending nine months out of the year here. Both of her eyes have good vision at
|
|

Conjunctival Vascular Anomaly812 viewsPatient presents a vascular pattern of blood vessels @ 10 o'clock of the superior-temporal quadrant of the right eye. Patient has had flare ups with anterior scleritis in the past which is controlled by Methotrexate. Patient's VA is currently 20/40 with PH 20/30, right eye.
|
|

Idiopathic Central Serous Retinopathy - Bilateral - Acute 811 views49-year-old man decreasing vision in the left eye for one week. He is not taking any steroid or steroid-related products. His blood pressure as far as he knows is under control.
VISUAL ACUITY: OD 20/30, OS 20/400
|
|

Serpiginouse Choroiditis (Chorioretinitis) - Acute Right Eye - Old Left Eye VA 20/25 OD , 20/50 OS811 views63-year-old woman has serpiginous choroiditis (date - March 2011). The right eye has not been previously involved, and then she noticed new onset floaters in the right eye for the last two weeks. Her vision in the right eye is hazy because of that.
VISUAL ACUITY: Vision OD is 20/25, OS is 20/50
|
|

Gyrate Atrophy - 15 year old male - 20/25 vision both eyes - Positive Family History811 views15 year old male was diagnosed with “retinitis pigmentosa†at age seven. The patient reports that his night vision is poor. He reports he does not notice a visual field change. He reports that his maternal grandfather has lost vision and a cousin has lost vision as well. He reports he has an uncle with some visual changes.
The most significantly affected relative is a 26-year-old legally blind cousin.
20/25+ OD, 20/25 OS.
|
|

Retinitis Pigmentosa - Leber's Congenital Amaurosis - 7 Year Old Child811 views7-year-old child who trips over things that the other children do not have trouble seeing. She is the only person in the family tree that the mother knows has any vision problems. Vision is 20/20 in each eye
|
|

Angioid Streaks - Peau D'Orange - Pseudoxanthoma Elasticum - Asymptomatic Extrafoveal Choroidal Neovascular Membrane811 views60-year-old woman has pseudoxanthoma elasticum since 2008. Her sister has the same problem and lost vision in both eyes. She had a problem with blood vessel growth in the left eye for which she had injections of Avastin in August, September, and October of 2011 (5 months ago). Subsequent to that, the macula has been dry and you have just been watching her carefully. She is in Florida for a short time but will ultimately be spending nine months out of the year here. Both of her eyes have good vision at
|
|

Purtscher's Retinopathy811 views19 year old female after pregnancy
|
|

Acute Posterior Multifocal Placoid Pigment Epitheliopathy - APMPPE - InfraRed Photo811 views 25-year-old man with one and half weeks ago he woke up with night chills. Also around that time his joints started hurting him. He also has headaches, although the headache at this point is not severe. His vision has been changing for about the last week and a half. He sees some spots in his vision and they are blurred spots. They are not in the central vision.
VISUAL ACUITY: OD 20/32, OS 20/32
|
|

Proliferative Diabetic Retinopathy and Mild Vitreous Hemorrhage810 views58-year-old woman has diabetic retinopathy in both eyes with neovascularization of the optic nerve, worse in the right eye than the left eye. Vision OD is 20/25, OS is 20/20
|
|

Cilioretinal artery occlusion and Ophthalmic Artery Occlusion with Relative Sparing of the Central Retinal Artery810 views80-year-old woman who says she was looking in the mirror, covered her right eye and noticed she could not see well out of the left eye. That just happened yesterday. Her last eye check was a few years ago. She also had a carotid endarterectomy on the right side in 2006 shortly after coronary bypass surgery. OD is 20/40, OS is 20/200.
|
|

Reticular Macular Disease (Pseudo-drusen) Both Eyes - Wet AMD OS - Dry AMD OD InfraRed810 views84-year-old woman has wet age-related macular degeneration in the left eye and dry macular degeneration in the right eye. She takes the eye vitamins and her vision is stable since she was treated three months ago with Avastin. OD 20/50, OS 20/32
|
|

X-linked Juvenille Retinoschisis - Peripheral Retinal Vascular Anomalies - Vitreous Hemorrhage - 8 Year Old Boy810 views8-year-old child OD 20/40, OS 20/50
OD: Vertical C/D ratio is 0.2. There are foveal cysts. There is also a retinal elevation inferiorly and there are patchy peripheral retinal hemorrhages.
OS: Vertical C/D ratio is 0.2. There are foveal cysts. There is peripheral retinal issues with some hemorrhage in some areas of peripheral retinoschisis.
|
|

Drusen Maculopathy - Confluent Subfoveal Soft Hydrophobic Drusen - AMD OU- OCT Line Scan Shows Thickening Under Retina with Retinal Thinning809 views73-year-old woman. She is diabetic for thirteen years. She is also on Coumadin for her heart disease.
VISUAL ACUITY: OD 20/25, OS 20/50.
|
|

Multiple Evanescent White Dot Syndrome - Acute Idiopathic Blind Spot Enlargement809 views33-year-old woman one week ago she awoke and saw a red spots flashing out of her right eye. She notices them to the right side, which is the temporal visual field out of the right eye, then they changed to bursts of white lights without colors and then she notices straight ahead a couple spots. She has headaches in the back of her head. OD 20/20, OS 20/20
|
|

Branch Retinal Arterial Occlusion 20/20 Vision - Symptoms for 1 Day809 views
|
|

Choriodal Neovascular Membrane - Subfoveal - Pseudo-Retinitis Pigmentosa - 50 years post Retinal Detachment Repair809 views86-year-old with a history of decreased vision in the right eye. The patient reports she has lost vision in the right eye over the past two months or so. She reports the vision was always compromised in that eye since retinal detachment surgery 50 years ago with a scleral buckler. Vision dropped from 20/50 to 20/200 right eye in 2 months.
|
|

Cilioretinal artery occlusion and Ophthalmic Artery Occlusion with Relative Sparing of the Central Retinal Artery809 views80-year-old woman who says she was looking in the mirror, covered her right eye and noticed she could not see well out of the left eye. That just happened yesterday. Her last eye check was a few years ago. She also had a carotid endarterectomy on the right side in 2006 shortly after coronary bypass surgery. OD is 20/40, OS is 20/200.
|
|

Central Retinal Artery Occlusion with Cilioretinal Sparing - Acute - FA Very Slow Filling CRA809 views 77-year-old man was doing fine until midnight of last night when he noticed sudden severe vision loss in the left eye. VISUAL ACUITY: OD 20/20, OS 2/200.
|
|
| 17965 files on 180 page(s) |
 |
 |
 |
 |
 |
14 |  |
 |
 |
 |
|